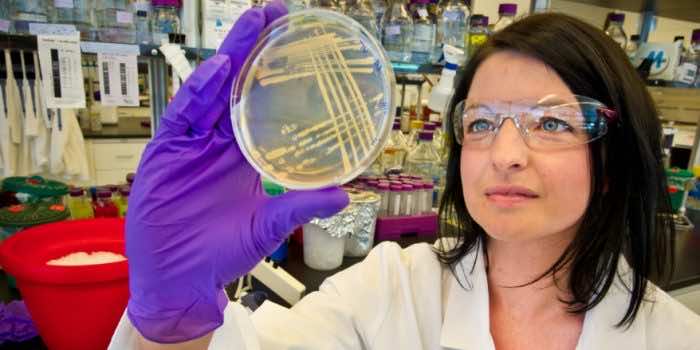

化石燃料对环境构成严重威胁。虽然我们经常听说太阳能和电动汽车,但在某些领域并没有太多实际的替代方案。煤油和其他航空燃料由于其高能量密度是这个行业的理想选择;然而,要取代它们也很有挑战性。
为了弥补这一差距,来自劳伦斯伯克利国家实验室、联合生物能源研究所、桑迪亚国家实验室、太平洋西北国家实验室和加州大学伯克利分校的研究人员开始对一种细菌进行实验。他们诱导它产生了一种高能量密度的分子,这种分子可以成功地用于生产可再生航空燃料。
“我们的动机是迫切需要替代石油衍生燃料的替代燃料。我们认为,这是减缓气候变化步伐的非常重要的一步,”丹麦技术大学DTU Biosustain的微生物学家、这项新研究的作者巴勃罗·克鲁兹-莫拉莱斯说。

“利用细菌制造聚环丙烷燃料(具有多个三角形碳图案的燃料)是可能的。这意味着,这些很难用传统化学方法制造的燃料,可以通过发酵过程可持续地制造出来。”
在加州大学伯克利分校的化学工程师杰伊·科斯林(Jay Keasling)带着他所谓的“爆炸性概念”找到克鲁兹-莫拉莱斯之后,研究人员开始寻找用细菌制造航空燃料的方法。
Jawsamycin含有5个手性环丙烷环,引起了Keasling的兴趣。这种化学物质具有抗真菌作用,它针对形成真菌细胞壁的关键酶。Jawsamycin是由链霉菌属的普通土壤细菌产生的。

当细菌摄入葡萄糖和氨基酸时,它们会将其分解,将食物转化为碳-碳键的基本组成部分,就像人体制造和储存脂肪一样。
这些碳键是由三个碳原子组成的三角形环丙烷环。这种形式使键发生弯曲,这就需要能量。
然而,尽管有诱人的品质,jawsamycin却很难生产。因此,研究人员发现并修补了负责jawsamycin产生的基因,并产生了一种新的碳化合物。
“我们实际上把它命名为fuelimycin(我知道这是个愚蠢的名字)。它的特殊之处在于它有多个三碳环;这些环很难用化学方法制造。这种分子自然存在的事实证明了大自然的惊人力量,”克鲁兹-莫拉莱斯说。
“这比引人注目的火箭应用更重要,因为到目前为止,还没有替代RP-1(用于宇宙飞船)、Jet-A(用于商用飞机)和汽油(用于船舶)的实际选择,这些都是空间有限的高耗能应用。例如,如果火箭携带大量燃料(如航天飞机使用的氢氧燃料),效率就会降低;电动飞机无法携带跨越大洋所需的巨大电池;轮船仅靠电力就无法跨越大西洋;如果使用核能,可能会对环境或国家安全构成威胁。”
然后,这个分子需要像现在的生物柴油一样,在较低的温度下点燃。当这种生物燃料被点燃时,就有足够的能量将火箭发射到太空中。

然而,目前的问题是如何扩大这种高能量密度环丙烷分子的生产。
“在扩展任何生物过程以生产任何产品时,人们都面临许多挑战。这些挑战包括提高滴度、速率和产量,以及让细菌在大规模(数十万到数百万升的发酵罐)中表现得像在实验室(小规模)中那样,”克鲁兹-莫拉莱斯说。
研究结果发表在该杂志上焦耳.